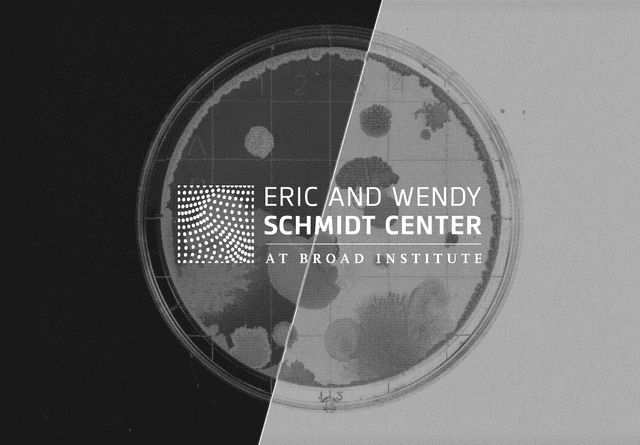
Computer vision in healthcare

Prof. Marcos Lopez de Prado
Global Head of Quant R&D at ADIA, Cornell Professor, and bestselling author on financial machine learning.

Prof. Caroline Uhler
MIT Professor and Co-Director at the Broad Institute, expert in machine learning, statistics, and causal inference.

Prof. Guido Imbens
2021 Nobel Laureate in Economics, Stanford Professor, and leading authority on causal inference.

Crowdsourcing has a very important role to play in investing. Firms turn investing problems into forecasting problems, then outsource to global researchers.
Prof. Marcos Lopez de Prado
Global Head of Quantitative R&D at ADIA
Client: Broad Institute of MIT & Harvard
The Schmidt Center needed to enhance computer vision algorithms for cell discovery without compromising patient data privacy.
The Result: The Crunch network generalized financial modeling architectures to solve biomedical vision tasks, achieving 76.7% accuracy in identifying causal roles and outperforming internal benchmarks by 2x.

Client: ADIA Lab
Distinguishing true cause-and-effect from simple correlation is the hardest challenge in big data. ADIA Lab challenged the network to find causal drivers in high-dimensional datasets.
The Result: The network successfully identified true causal graphs, outperforming the client's internal best models by 17%. This framework is now used to detect "false positives" in massive datasets.

Client: ADIA Lab
Real-world data is rarely static: energy grids, supply chains, and sensor networks suffer from sudden "regime shifts" that break standard predictive models. ADIA Lab challenged the network to build adaptive algorithms that detect these invisible shifts in real-time.
The Result: The winning models demonstrated "Dynamic Adaptation," instantly unlearning irrelevant historical data to fit new patterns. The network achieved double-digit percentage improvements over standard baselines, creating resilient systems that don't fail when the environment changes.
The Problem: Your R&D capacity is limited by headcount, budget, and recruitment cycles. Hiring top-tier PhD talent takes months, and internal teams often operate in silos, limited by their own biases.
The Solution: Crunch runs encrypted ML competitions on your specific predictive challenges. Thousands of global data scientists and researchers compete to build superior models. You get breakthrough performance and novel IP. They never see your raw data.
Seamless path from competition to deployment with enterprise-grade infrastructure
Access 11,000+ ML engineers and 1,200+ PhDs. Our network includes researchers from top institutes specializing in Causal Inference, Computer Vision, and Deep Learning, competing to solve your edge cases
Competitions designed by leading researchers from Stanford, Cornell, and Abu Dhabi Investment Authority Lab
Access models through simple APIs or deploy on-premise. Whether for batch processing or real-time inference, the Crunch Engine works with your existing infrastructure
TEE-based privacy (Trusted Execution Environments) ensures models run encrypted. Deploy in your cloud or on-premise with full data control. Your proprietary data never leaves your secure perimeter
From high-frequency pricing to real-time computer vision, our ensemble models are optimized for low-latency environments and high-throughput demands
Translate your business objective into a machine learning challenge on the Crunch Hub. Whether it's time-series forecasting, computer vision, or optimization.
Run from 3-month sprints to evergreen, never-ending competitions. Collect diverse solutions from elite researchers. Crunch handles the compute, GPUs, and leaderboard while your data remains obfuscated.
From day one of your Crunch competition, Crunch is orchestrating all the participants models behind a simple API.
Organizers can use Python to infer, retrain and test any model at any time. They can also deploy model containers in the cloud or on-premises to easily access the models.
Winners are always identified on out-of-sample or live data hold out . Sometime on a period as long as 6 months of live data such as for the ADIA Lab Market Prediction Competition. Crunch handles the payment of the reward, including complete KYC of all winners.
Deploy the selected model structure to production with institutional proof and ultra-low-latency infrastructure.